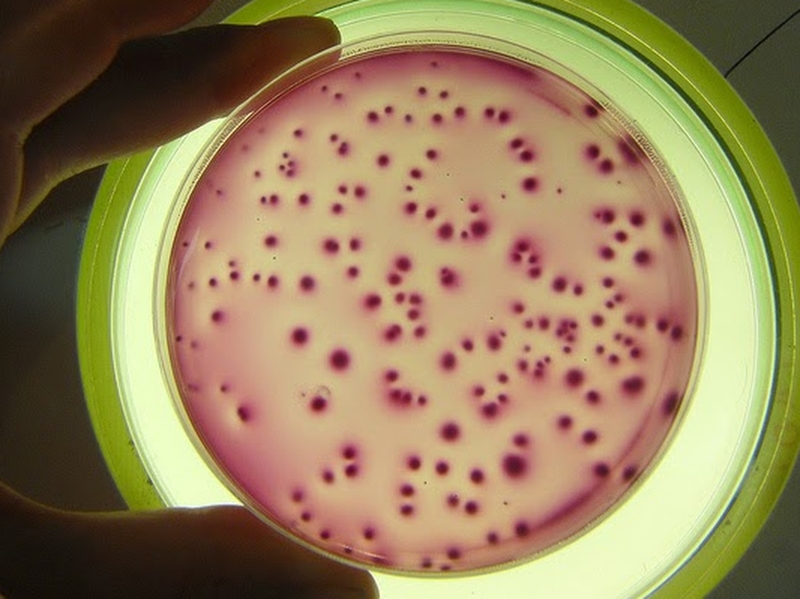
Xét nghiệm vi sinh là gì? Vì sao phải làm xét nghiệm vi sinh? 5

Tốt nghiệp đại học Khoa Dược. Có kinh nghiệm hơn 10 năm trong lĩnh vực Dược phẩm, tư vấn thuốc và thực phẩm chức năng. Hiện đang là giảng viên cho Dược sĩ tại Nhà thuốc Long Châu.
Thục Hiền
09/08/2024
Mặc định
Lớn hơn
Trong bối cảnh y học hiện đại ngày càng phát triển, bên cạnh những tiếp cận lâm sàng ban đầu thì các chỉ số xét nghiệm cận lâm sàng là cơ sở quan trọng giúp đội ngũ y bác sĩ chẩn đoán chính xác các tình trạng bệnh tật của người bệnh. Xét nghiệm vi sinh là chỉ số cận lâm sàng hàng đầu trong hỗ trợ chẩn đoán và điều trị bệnh lý liên quan đến nhiễm trùng.
Xét nghiệm vi sinh bao gồm nhiều xét nghiệm thành phần với nhiều phương pháp khác nhau và tùy từng loại bệnh nhiễm trùng mà chuyên gia y tế sẽ có chỉ định phù hợp. Vậy xét nghiệm vi sinh là gì? Vì sao phải làm xét nghiệm vi sinh?
Xét nghiệm vi sinh là quá trình kiểm tra và phân tích các mẫu bệnh phẩm như mẫu mô, chất lỏng hoặc các vật liệu sinh học khác để phát hiện, xác định sự hiện diện và chẩn đoán hình ảnh của vi khuẩn, vi rút, nấm và các vi sinh vật khác. Xét nghiệm vi sinh thường được thực hiện trong lĩnh vực y tế để hỗ trợ chẩn đoán, tìm ra nguyên nhân gây bệnh và điều trị các bệnh do vi sinh vật gây ra.
Phạm vi áp dụng của xét nghiệm vi sinh đa dạng, có thể ứng dụng trong chẩn đoán, theo dõi, điều trị, dịch tễ học, nghiên cứu, giảng dạy hay lĩnh vực pháp lý.

Dựa vào phương pháp thực hiện, người ta có thể chia thành các loại xét nghiệm vi sinh như sau:

Theo thống kê, bệnh lý nhiễm trùng ngày càng phổ biến và là một trong những nhóm bệnh có tỷ lệ mắc cao hàng đầu ở Việt Nam bên cạnh các bệnh về tim mạch, tiểu đường, béo phì hay ung thư. Việc tự ý sử dụng kháng sinh để điều trị nhiễm trùng thay vì khám bệnh tại các cơ sở y tế đã dẫn đến tình trạng đề kháng thuốc ngày càng trầm trọng và việc chẩn đoán căn nguyên nhiễm trùng trở nên khó khăn. Chính vì vậy, xét nghiệm vi sinh được thực hiện nhằm:
Tóm lại, xét nghiệm vi sinh đóng vai trò quan trọng trong chẩn đoán, điều trị, kiểm soát dịch bệnh và phòng ngừa, giúp cải thiện chăm sóc sức khỏe và bảo vệ sức khỏe cộng đồng.

Xét nghiệm vi sinh là công cụ quan trọng trong chẩn đoán, điều trị, kiểm soát dịch bệnh và phòng ngừa, đóng góp vào nâng cao chất lượng chăm sóc sức khỏe và bảo vệ sức khỏe cộng đồng. Như đã đề cập ở trên, có 4 phương thức xét nghiệm vi sinh chính, nhà thuốc Long Châu sẽ trình bày về phạm vi ứng dụng chi tiết của từng phương pháp.
Xét nghiệm soi trực tiếp là một phương pháp quan trọng trong xét nghiệm vi sinh, được dùng kiểm tra mẫu mô, chất lỏng hoặc các vật liệu sinh học khác dưới kính hiển vi để phát hiện sự hiện diện và đánh giá các đặc điểm của vi sinh vật.
Một số ứng dụng chính của xét nghiệm soi trực tiếp trong xét nghiệm vi sinh:
Ưu điểm của phương pháp soi trực tiếp: Nhanh chóng, có tính tin cậy, phát hiện nhanh, chi phí thấp và ứng dụng đa dạng.
Tuy nhiên, xét nghiệm soi trực tiếp cũng có một số hạn chế, bao gồm khả năng giới hạn trong việc phát hiện các vi sinh vật nhỏ hoặc hiếm gặp, giới hạn độ phân giải, không xác định được loại vi sinh vật và sự phụ thuộc vào kỹ năng của nhân viên xét nghiệm.
Xét nghiệm soi trực tiếp là một công cụ quan trọng trong xét nghiệm vi sinh, giúp cung cấp thông tin nhanh chóng và đáng tin cậy về sự hiện diện và đặc điểm của vi sinh vật.

Xét nghiệm nuôi cấy là phương pháp trong vi sinh vật học để phát hiện và xác định vi sinh vật trong một mẫu xét nghiệm bằng cách đặt mẫu trên các môi trường nuôi cấy phù hợp để tạo điều kiện cho vi sinh vật sinh trưởng và phát triển. Sau đó, mẫu được kiểm tra để xác định loại vi sinh vật và tính chất của chúng.
Phạm vi ứng dụng của xét nghiệm nuôi cấy bao gồm:
Ưu điểm của phương pháp nuôi cấy: Xác định được loài, đánh giá được độ nhạy với kháng sinh, độ chính xác và tin cậy, ứng dụng đa dạng, có thể lưu trữ và xem lại.
Hạn chế của phương pháp này là tốn thời gian để vi sinh phát triển, không áp dụng được với loài không sinh trưởng, phụ thuộc vào chất liệu và điều kiện nuôi cấy, đòi hỏi chi phí và kỹ thuật cao.
Tóm lại, xét nghiệm nuôi cấy là một phương pháp quan trọng trong xét nghiệm vi sinh.
Trong xét nghiệm vi sinh, xét nghiệm miễn dịch là một phương pháp được sử dụng để phát hiện và định lượng các chất phản ứng miễn dịch có liên quan đến sự hiện diện của vi sinh vật trong mẫu xét nghiệm.
Phạm vi ứng dụng của phương pháp xét nghiệm miễn dịch bao gồm:
Ưu điểm: Độ nhạy và đặc hiệu cao, định lượng chính xác, đa dạng ứng dụng.
Hạn chế của phương pháp: Phụ thuộc vào kiến thức về chất phản ứng miễn dịch, chi phí cao, không thể phát hiện tất cả các vi sinh vật.
Xét nghiệm sinh học phân tử trong xét nghiệm vi sinh là một phương pháp tiên tiến, sử dụng các kỹ thuật và phương pháp phân tích phân tử để xác định, định lượng và phân loại các tác nhân vi sinh vật trong mẫu xét nghiệm.
Dưới đây là một số ứng dụng chính của xét nghiệm sinh học phân tử trong xét nghiệm vi sinh:
Ưu điểm: Độ nhạy và độ chính xác cao, tốc độ nhanh, khả năng phát hiện các biến thể, tự động hóa, tiêu chuẩn hóa, tiết kiệm mẫu và chi phí.
Hạn chế: Đòi hỏi kỹ thuật cao, thiết bị và cơ sở hạ tầng phức tạp, hạn chế phạm vi xét nghiệm, chi phí xử lý mẫu cao, đắt tiền.
Trên thực tế, xét nghiệm sinh học phân tử trong xét nghiệm vi sinh đang ngày càng trở nên phổ biến và quan trọng trong chẩn đoán và điều trị bệnh truyền nhiễm.
Xét nghiệm vi sinh đóng vai trò hết sức quan trọng trong việc hỗ trợ chẩn đoán và điều trị bệnh nhiễm trùng, vì vậy, người bị nhiễm trùng không nên tự ý sử dụng kháng sinh tại nhà mà nên tới cơ sở y tế để khám và thực hiện xét nghiệm vi sinh. Điều này giúp đảm bảo chẩn đoán chính xác và nhận được phác đồ điều trị thích hợp nhất để tránh tình trạng kháng kháng sinh trong tương lai.
Xem thêm:
Dược sĩ Đại họcNguyễn Thị Hồng Nhung
Tốt nghiệp đại học Khoa Dược. Có kinh nghiệm hơn 10 năm trong lĩnh vực Dược phẩm, tư vấn thuốc và thực phẩm chức năng. Hiện đang là giảng viên cho Dược sĩ tại Nhà thuốc Long Châu.